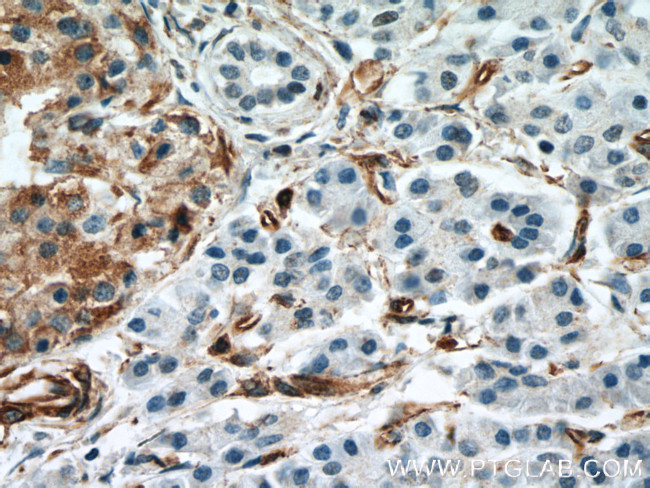
Amphiregulin Antibody in Immunohistochemistry (Paraffin) (IHC (P))

Search
Proteintech
Amphiregulin Monoclonal Antibody (1A1G9)
{{$productOrderCtrl.translations['antibody.pdp.commerceCard.promotion.promotions']}}
{{$productOrderCtrl.translations['antibody.pdp.commerceCard.promotion.viewpromo']}}
{{$productOrderCtrl.translations['antibody.pdp.commerceCard.promotion.promocode']}}: {{promo.promoCode}} {{promo.promoTitle}} {{promo.promoDescription}}. {{$productOrderCtrl.translations['antibody.pdp.commerceCard.promotion.learnmore']}}
产品信息
66433-1-IG
种属反应
宿主/亚型
分类
类型
克隆号
抗原
偶联物
形式
浓度
纯化类型
保存液
内含物
保存条件
运输条件
产品详细信息
Immunogen sequence: AGLDLNDTY SGKREPFSGD HSADGFEVTS RSEMSSGSEI SPVSEMPSSS EPSSGADYDY SEEYDNEPQI PGYIVDDSVR VEQVVKPPQN KTESENTSDK PKRKKKGGKN GKNRRNRKKK NPCNAEFQNF CIHGECKYIE HLEAVTCKCQ QEYFGERCGE KSMKTHSMID SSLSKIALAA IAAFMSAVIL TAVAVITVQL RRQYVRKYEG EAEERKKLRQ ENGNVHAIA (25-252 aa encoded by BC009799)
靶标信息
Amphiregulin (AR) binds to EGF-Receptor (EGFR) with lower affinity than EGF. The mature secreted form AR is an 84-amino acid residue glycosylated polypeptide growth regulator, which is generated by proteolytic processing of a 252-amino acid transmembrane precursor. Seven different polypeptide ligands, which derive from distinct genes, are capable of binding to the extracellular domain of EGFR. These ligands include EGF, TGFalpha, AR, HB-EGF, cripto-1, epiregulin, and betacellulin. All of these growth factors contain a characteristic EGF-like domain which is defined by 6 evenly spaced cysteine residues that generate 3 loops through the formation of disulfide bonds. AR protein has been localized by immunohistochemistry to the epithelium of the colon, stomach, pancreas, breast, and placenta. AR is reportedly overexpressed in human cancers of breast, colon, stomach, and pancreas.
仅用于科研。不用于诊断过程。未经明确授权不得转售。
生物信息学
蛋白别名: Amphiregulin; amphiregulin B; AR; Colorectum cell-derived growth factor; CRDGF; MGC13647; Schwannoma-derived growth factor; SDGF
基因别名: AR; AREG; AREGB; CRDGF; SDGF
UniProt ID: (Human) P15514, (Rat) P24338
Entrez Gene ID: (Human) 374, (Rat) 29183